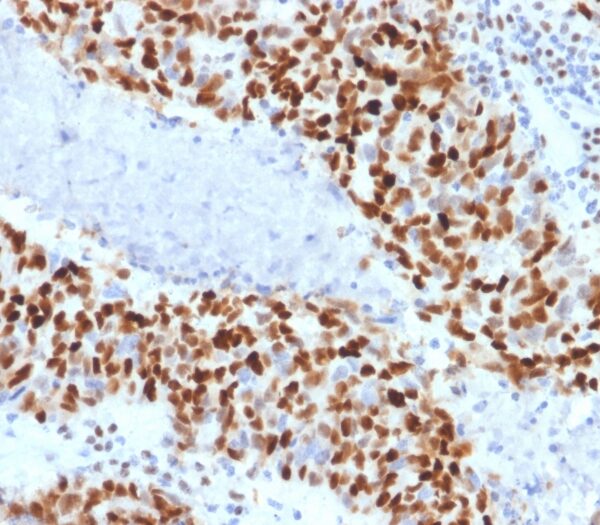

We boast a 98% rejection rate.
Our team of scientists have screened millions of antibodies in order to find best-in-class antibodies across the human proteome. Our portfolio of 10,000 monoclonal antibodies, amassed over the last decade, are highly validated for multiple applications and undergo strict quality assurance checks before we release them. NeoBiotechnologies’ antibodies are consistently the preferred choice among researchers and scientific institutions.